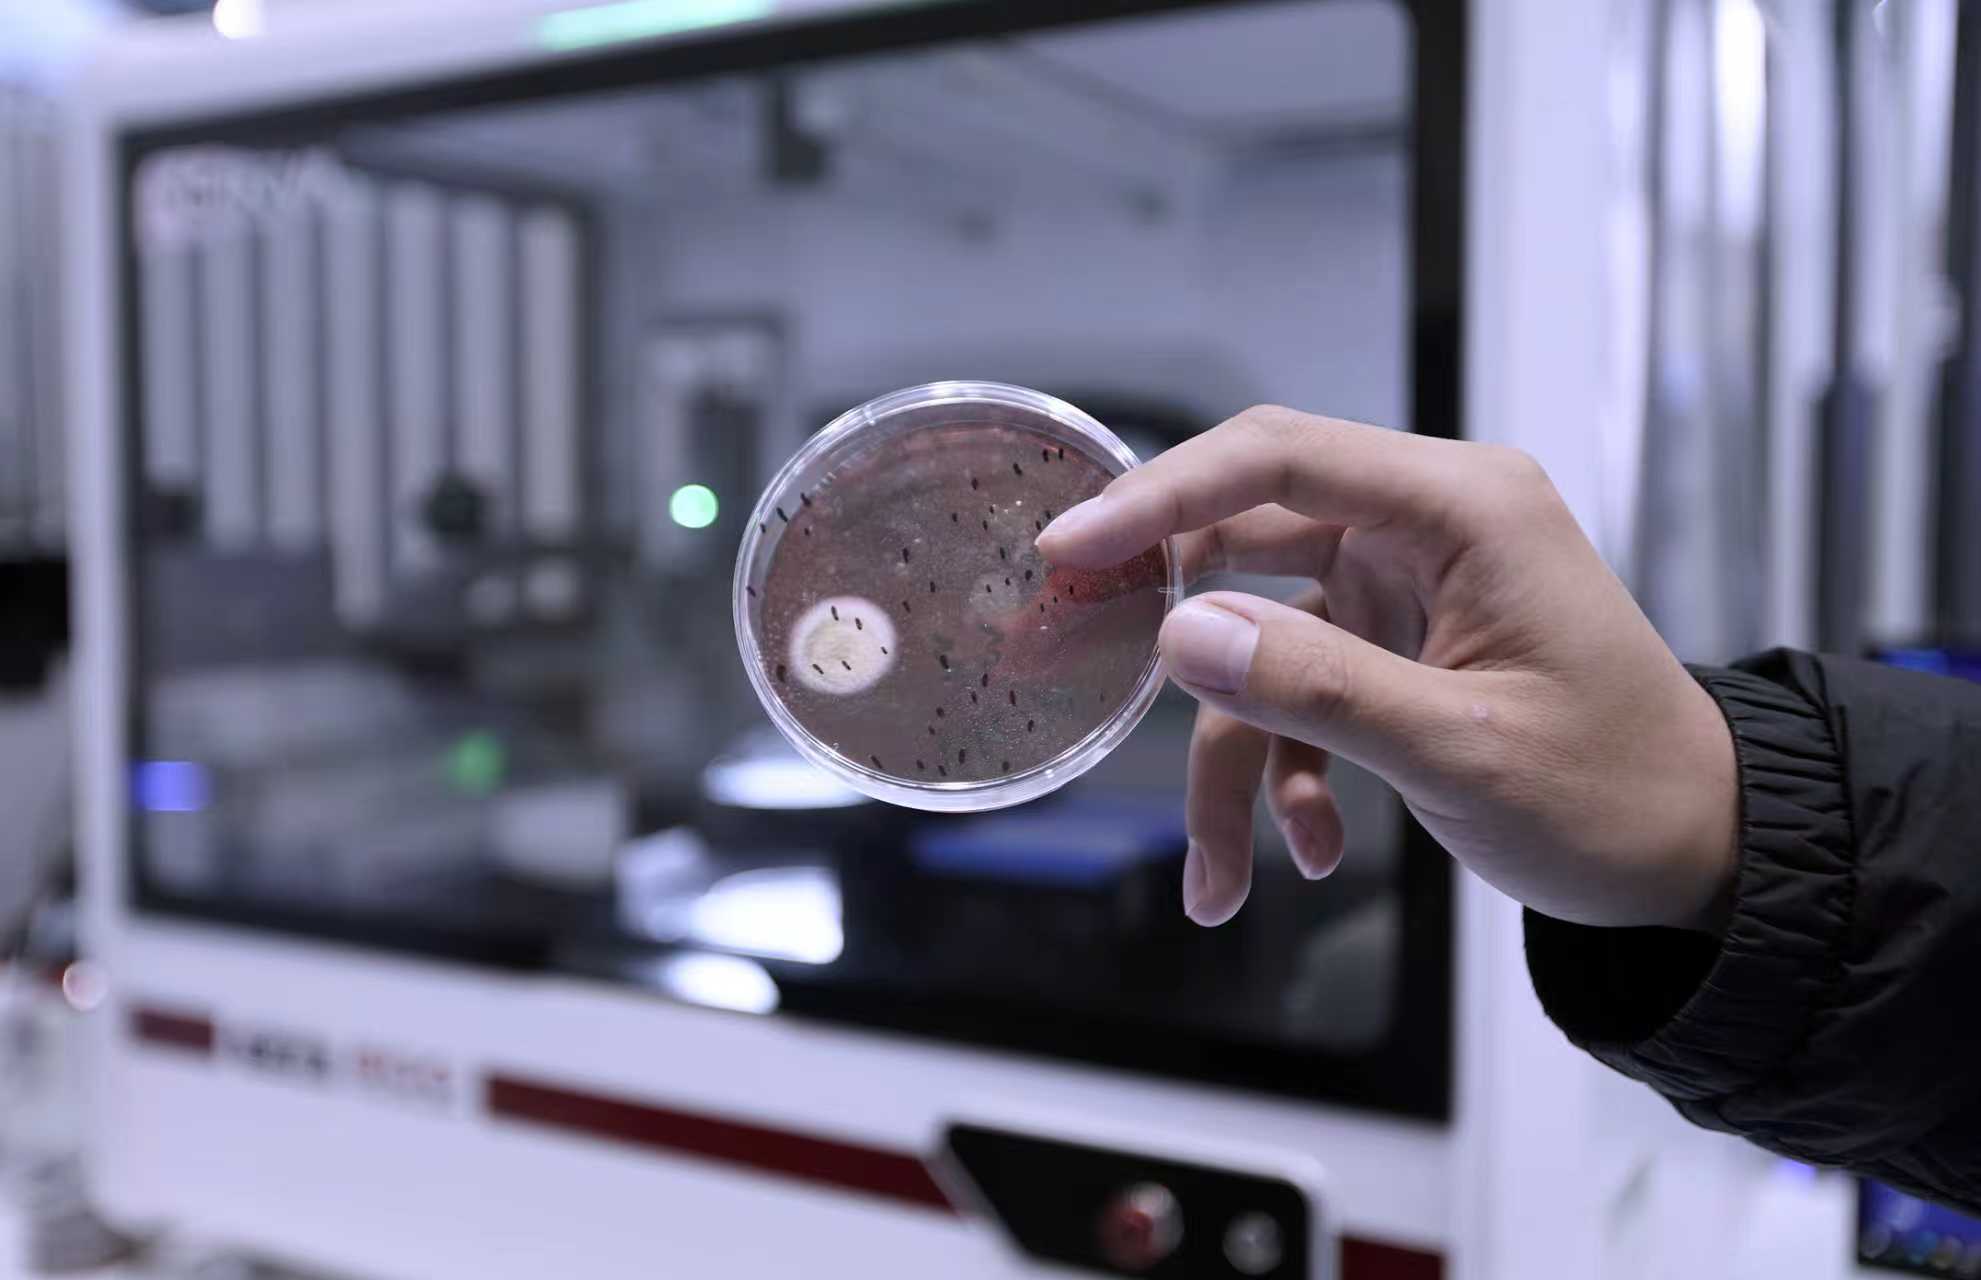

新坐标丨Y轴:科技创新,含“新”量几何?
孙良栋 来源:大众新闻·鲁中晨报
2025-10-29 15:46:10原创
无疑,科技创新是推动企业高质量发展的核心驱动力,新华医疗也不例外。
深入实施创新驱动发展战略,部署重点领域的科技攻关方向,从精准聚焦一个细胞的“生与死”、一只小白鼠的“幸福生活”,一个安瓿瓶的重要性,到全力攻克由几万、十几万枚零件组成的放疗重器,新华医疗科技创新的步伐,都给医疗器械行业带来了怎样的惊喜?
小白鼠蹚出实验科技新赛道
“每天早晨能看到它们还在自由自在地生活着,我们也就安心了。” 10月22日,新华医疗实验科技厂总经理赵国强指着厂里的“宝贝”——小白鼠,他告诉记者,“这就意味着,我们的实验动物产品构成的生态系统又平稳运行了一天。”
 实验“小白鼠们”在笼盒中自由自在地生活。
实验“小白鼠们”在笼盒中自由自在地生活。
只见在新华医疗实验科技厂的厂房内,笼盒机器人处理系统正在运行,只见一个个饲养笼盒被机械臂抓取、清洗、消毒、烘干,之后再被放上食物和水源。放眼望去,满墙的饲养笼盒仿佛组成了一个宏大的生态系统,一只只小白鼠在里面悠然饮食。
一款特效药,一剂新疫苗是如何问世的?
“一项新的科研成果,无论是用于教学研究还是药物疫苗研发,都是从最基本的细胞实验或者动物实验出发的。”赵国强表示,在生命科学、生物医药、食品、农畜禽业等领域,实验室动物设备设施是保障实验动物福利、降低生物安全风险的基础,在未来实验室的发展中,更加智能化的实验室动物设备设施也是不可或缺的一部分。
 新华医疗实验科技厂。
新华医疗实验科技厂。
新华医疗从2009年开始进军实验科技新赛道,2013年成立独立运营的分厂,即实验科技厂,围绕实验动物和实验室领域加快技术研发,目前已形成实验动物设备、实验室设备及生物安全实验室设备三大产品体系的产品布局。
“如何保证实验动物的最佳状态,减少人工饲养的影响,为此,我们突破国外垄断的关键技术,开发了全自动笼盒处理系统,像小白鼠、兔子这种实验动物的饲育全程实现了自动化。”赵国强介绍,作为实验动物系统化解决方案的开拓者与领导者,实验科技厂致力于为实验室领域及实验动物领域广大用户提供系统化的解决方案,国内每9个实验室有6个在用全自动笼盒处理系统,市场占比超过50%。
如今,作为国内实验动物设施智能化标杆项目,由新华医疗实验科技厂建设的国内首家智慧化实验动物中心正在齐鲁医院使用。
新华医疗实验科技厂实验室产品让现代科研更高效、更严谨。
新华医疗实验科技厂实验室产品让现代科研更高效、更严谨。
“像实验用的真菌、细菌乃至细胞,传统的人工培育和计算统计的方式已经不适应现代科研,我们以实验自动化为突破方向,成立了实验室自动化产品线,产品涵盖菌落计数器、细胞计数器、全自动培养箱、全自动化细胞构建系统等20余种自动化智能化产品,提供单机和系统化解决方案,重点攻关‘卡脖子’技术、‘国产替代’仪器设备,为我国实验室科研工作高质量发展提供有力支撑。”新华医疗实验科技厂实验室产品线经理刘震告诉记者。
 机器人正在清洗笼盒。
机器人正在清洗笼盒。
此外,新华医疗实验科技厂还引入了“黑灯工厂”概念,开发了全自动细胞培养系统,在高度自动化、数字化、智能化的条件下,保证实验的持续、高效、精准、安全运行,实现实验操作的可重复性,提高实验结果的准确性。
深耕科技创新,新华医疗实验科技厂在实验动物领域走出了一条从“跟跑”到“并跑”,再到“领跑”行业的“智慧”动物实验之路。
小安瓿瓶撬动“卡脖子”大突破
“护士,这个点滴怎么是塑料包装,安不安全啊?”在日常就医场景中,我们时常会听到这样的疑问。
在人们的固有认知里,打点滴就是把玻璃安瓿瓶的药打进生理盐水中然后再进行输液,而对于塑料安瓿瓶,患者或多或少都会在心里打上一个问号。
“塑料安瓿瓶比玻璃安瓿瓶包装要更安全、更可靠,尤其是塑料安瓿瓶在开封取药的过程中,具有无玻璃碎屑风险,开启更便捷,降低药液飞溅风险,无消毒瓶颈等优势。”新华医疗制药科技集团小容量产品线总监黄利军告诉记者,这份更高的安全和可靠,背后是新华医疗灌装药机产品的智能制造水平。
 正在调试中的“BFS”设备。
正在调试中的“BFS”设备。
在新华医疗制药科技集团的生产车间,一台台“BFS”正在紧张安装和调试,数字化工厂监控中心生产协同智联平台大屏上,从订单展示、订单完成情况,到协同任务数量等信息一应俱全。
“这是四川一家制药公司定制的高速连续式‘BFS’,它的生产效率可以达到每小时灌装20000支塑料安瓿瓶。”黄利军介绍。
“BFS”是塑料瓶吹灌封一体机的简称,此设备在制药行业主要用于生产塑料瓶安瓿、滴眼剂、吸入剂、大输液以及医美产品等,应用非常广泛。其主要工艺流程为采用颗粒状PP或PE料,经过挤出机的高温融化,形成塑料管胚,管胚在瓶型模具中成型、灌装、封口,然后经过冲裁机将产品废料去除,形成最终产品,可以实现产品的无菌灌装,其制药工艺较传统的工艺具有明显的优势。
 塑料安瓿瓶具有无玻璃碎屑风险,开启更便捷,降低药液飞溅风险,无消毒瓶颈等优势。
塑料安瓿瓶具有无玻璃碎屑风险,开启更便捷,降低药液飞溅风险,无消毒瓶颈等优势。
“‘BFS’起源于上世纪60年代,此前,德国某公司拥有最先进的吹灌封一体技术,具备世界领先水平,严重制约着国内无菌制剂药品生产厂家的发展。”黄利军说。
面对“BFS”产品潜力巨大的市场,2014年初,“BFS”项目在制药科技集团正式上马,成立了仅有8人的研发团队。为了加快“BFS”的研发进度,借助集团优势推进项目发展,2015年事业部向集团领导申请成立新品十八部,将BFS的研发进度送入了快车道。
“研发团队深感责任之重大,研发团队在人员不足,缺乏借鉴资料的前提下,凭借丰富的研发经验和无私的奉献精神,克服重重困难,在短短两个月的时间里,完成了第一代产品的图纸设计工作。”回忆起那段大家团结一心研发的日子,黄利军感慨不已,“如今,我们的连续式‘BFS’具有无菌保障性高、占地面积小等优点,能满足最终高温灭菌的要求,而且其材料利用率更高,能够极大地降低生产制造成本,代表着BFS技术未来的发展方向”
从跟跑到领跑,相比国外产品往复式“BFS”,新华医疗制药科技集团自主研发的连续式“BFS”,材料利用率从40%提高到了70%以上,生产效率由11000支/小时提高为最高可达45000支/小时。
“双模高速连续式BFS设备研发成功,不仅解决了我国在连续式‘BFS’技术领域被国外‘卡脖子’的局面,还可以为药品生产企业提供更高品质的生产技术工艺,为人民健康提供更安全的生产保障。”黄利军说,同时,项目还通过核心设备的生产带动上游配液、下游灭菌、包装等一系列设备的研发,将带来一场中国输液革命。
0.5毫米的一小步,肿瘤诊疗的一大步
“我们研发的智能环形医用电子直线加速器已通过国家药品监督管理局的产品注册审查,成功取得了三类医疗器械注册证。”说起今年最新的科研成果,新华医疗放射诊疗产品事业部产品技术部负责人刘文锋喜不自胜。
 智能环形医用电子直线加速器。
智能环形医用电子直线加速器。
肿瘤诊疗,作为当前医疗发展面临一大难关,因诊疗设备属于高精密仪器,上万枚、十几万枚零件涉及众多专利,且学科交叉度高,长期以来被国外垄断,价格居高不下,医院和肿瘤患者的负担都很重。
而今年,新华医疗携新产品——新华泰阿智能环形在线自适应放疗系统(简称“新华泰阿”)亮相欧洲放射治疗与肿瘤学学会大会,展现了其在精准放疗领域的创新能力。
作为医疗器械领域的关键高端装备,环形加速器技术一直是衡量行业科技实力的重要标志之一。
“我们组建了核心研发团队,历经长期技术攻关,在‘智能环形加速器系统’研发中突破多项核心技术瓶颈,从加速器磁场精准控制、束流稳定性优化,到智能化运维系统搭建,每一个技术环节都实现了自主创新,不仅填补了相关领域技术空白,更在设备能效、运行精度、安全防护等关键指标上达到国际先进水平。”刘文锋介绍。
据了解,该系统的成功研发与应用,将为肿瘤放射治疗、医学影像诊断等临床领域提供更高效、更精准的技术支撑。
 医用加速管。
医用加速管。
“我们这款新形智能环形加速器,相对传统加速器在治疗精度和效率上都有大幅度的提升,比如治疗等中心精度由1毫米提高到0.5毫米以内,这0.5毫米提升,我们项目团队花费两年多的时间攻克,对患者来说大大降低了治疗副作用,治疗效率由每小时治疗5个患者提高到10个患者以上。”刘文锋告诉记者,相较于传统设备,智能环形加速器系统具备治疗精度更高、患者治疗时间更短等显著优势,能有效提升临床治疗效果,同时降低医疗操作复杂度,为医疗机构提供更优质的解决方案,对推动医疗器械产业向高端化、智能化升级具有重要意义。
据了解,这款产品还集成了先进的图像引导技术、智能算法和自适应放疗理念,能够实现放疗过程的实时监测肿瘤位置变化做出动态调整,从而进一步提高肿瘤的疗效和对正常组织的保护。
在国内新品鉴定会(苏、浙、皖专场)上,专家对新华泰阿系统的一键质控效率、影像质量及剂量稳定性进行实测,充分肯定其临床转化潜力。目前,新华医疗已与沙特、土耳其、肯尼亚及东南亚多国达成合作意向,彰显了“中国智造”的国际竞争力。
让更多患者受益于突破性科技创新成果,新华医疗,一直在路上。
(大众新闻·鲁中晨报记者 孙良栋 王继洋 王兵 通讯员 平字孟)
责任编辑:李中丽
